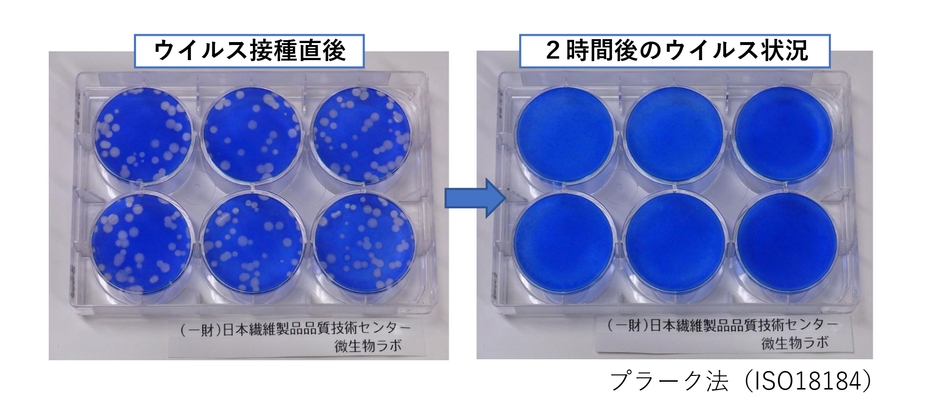
エビデンス1

拭き取り手間いらず!!超速乾除菌スプレー 『スーパーアルコールシャワー』 抗ウィルス成分追加で新登場
除菌+消臭効果、安全性の高い植物由来の抗ウィルス成分配合
株式会社パイン・クリエイト(本社:愛知県名古屋市、代表取締役:松井 敏郎)は、生活の様々なシーンで使用できる超速乾除菌スプレー「スーパーアルコールシャワー」に抗ウィルス成分を配合、リニューアルして、2021年6月10日から販売開始いたします。

「スーパーアルコールシャワー」開発の背景
パイン・クリエイトではこれまで、カラオケマイク専用の除菌消臭スプレーの開発を主に行ってきました。精密機械であるマイクの故障の原因にならないよう、特殊ノズルと成分配合比によって超速乾を実現、またマイクヘッドは人の口が触れる可能性のある部分の為、高い安全性も確保しております。
これらのノウハウを生かし、生活の様々なシーンで幅広くご使用いただけるように新たに開発したのが「スーパーアルコールシャワー」です。
「スーパーアルコールシャワー」の特長
1.超速乾で拭き取りの手間いらず
特殊ノズルと成分配合比により、超速乾を実現。
シュッとひとふきで除菌効果があり、液だれしないので拭き取りの手間がいりません。

2.除菌+消臭効果
アルコールに加え、柿タンニンを使用した除菌剤の効果により、消臭も行います。
3 植物由来の抗ウィルス成分配合
植物が原料の安全性の高い、抗菌・抗ウィルス成分を追加しました。


使用例
飛沫防止パーテーション、ドアノブ、テーブルや椅子、トイレ周辺、手すりなど、様々な場所にご利用いただけます。
※目立たない場所でお試しの上、ご使用ください。




■2021年6月9日(水)より開催の『食中毒・ウィルス対策展』(東京ビッグサイト 青海展示場)にて商品展示
2021年6月9日(水)~11日(金)まで、東京ビッグサイト青海展示場にて開催の『食中毒・ウィルス対策展』に出展します。期日内は実際に「スーパーアルコールシャワー」をお手にとって、その速乾性をお試しいただくことができます。
その他にも感染予防アイテムを展示予定です。
「スーパーアルコールシャワー」の概要
名称 : スーパーアルコールシャワー
容量 : 500ml
成分 : エタノール、柿タンニン由来の除菌剤、抗菌・抗ウィルス剤、ガス
販売開始日: 2021年6月10日
販売料金 : 980円(税込)
販売店 : インターネット通販 他
URL : https://eisei-marupa.com/
会社概要
商号 : 株式会社パイン・クリエイト
代表者 : 代表取締役 松井 敏郎
所在地 : 〒444-2135 愛知県岡崎市大門2丁目2-1
設立 : 1990年9月
事業内容: アミューズメント施設用商品の開発
資本金 : 1,000万円
URL : https://marupa.co.jp/
本製品に関するお客様からのお問い合わせ先
株式会社パイン・クリエイト
Tel:0564-24-0505